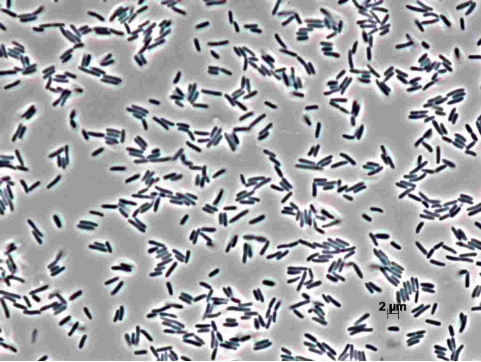
Hình 3: Một ổ vi khuẩn Pseudomonas savastanoi dưới kính hiển vi

Đậu tương hay đậu nành là cây họ đậu giàu dinh dưỡng và protein được trồng làm thức ăn cho người và các loại gia súc. Trong đời sống hàng ngày, các sản phẩm từ đậu tương được khá nhiều người ưa chuộng và ứng dụng với số lượng lớn như việc sử dụng trực tiếp hạt hoặc các sản phẩm từ đậu nành như đậu phụ, dầu đậu nành, nước chấm, bánh kẹo, sữa đậu nành… Ngoài ra, bộ rễ của cây đậu tương còn có tác dụng cải tạo đất bằng cách tăng lượng nitơ trong đất và hỗ trợ năng suất của các loại cây trồng khác. Việc canh tác và trồng đậu tương cũng rất dễ dàng nên bà con một số vùng thường chọn loại cây này để xen canh sản xuất kinh tế và đã mang lại thu nhập cao. Tuy rằng kỹ thuật canh tác rất dễ nhưng cây đậu tương cũng dễ mắc các bệnh như nấm, thối thân,… một trong số các bệnh đó không thể thiếu là bệnh đốm lá do vi khuẩn gây ra. Vậy dấu hiệu nào để bà con nhận biết và cần xử lý như thế nào khi bệnh xuất hiện trên đồng ruộng. Mời bà con tham khảo cùng chúng tôi nhé.
Bệnh đốm lá vi khuẩn gây hại trên cây đậu tương
Bệnh đốm lá do vi khuẩn gây hại trên cây đậu tương còn có tên gọi khác là bệnh vết phồng vi khuẩn hay bệnh đốm ướt. Bệnh do một loại vi khuẩn có tên Xanthomonas phaseoli pv. sojense gây ra và lây lan trên cây đậu tương gây ảnh hưởng đến năng suất sản lượng của bà con. Sau bệnh rỉ sắt thì đây chính là căn bệnh phổ biến trên trên cây đậu tương. Ở một số vùng chuyên canh sản xuất đậu tương lớn trên thế giới như bang Illinois của Mỹ, hầu hết các giống đậu tương tại đây đều bị nhiễm bệnh và bệnh có thể tồn tại mầm bệnh qua hạt giống. Loại vi khuẩn này ưa thích và phát triển mạnh ở điều kiện nhiệt ấm và chúng lây lan từ năm này qua năm khác bằng lá hoặc tàn dư của vụ mùa trước. Vì bệnh rất dễ sinh sôi và phát triển, đặc biệt là sau thời kỳ ra hoa và đậu quả nên bà con chú ý cần thường xuyên thăm ruộng đồng để đề phòng bệnh phát triển và sớm có biện pháp xử lý kịp thời.
Đối tượng gây hại
Cây đậu tương là đối tượng chính mà bệnh đang tấn công và gây hại. Bệnh tấn công trực tiếp lên hầu hết các bộ phận cây đậu tương như thân, cành, quả và lá. Bệnh tấn công ngay từ những cây mầm giống đến các cây trưởng thành, tuy nhiên đa số bệnh chỉ phát triển mạnh ở giai đoạn cây đã ra hoa đậu quả thành công và đa số chúng tấn công lên phần lá.

Dấu hiệu bệnh đốm lá do vi khuẩn
Thông thường các triệu chứng của bệnh đốm lá do vi khuẩn thường xuất hiện vào đầu mùa và bà con có thể dễ dàng nhận biết được. Đặc trưng của bệnh này là các vết đốm nhỏ với kích thước khoảng 1 – 2 mm. Các vết đốm này thường không có hình dạng cụ thể và có màu xanh hơi vàng ở phần rìa xung quanh, phần tâm chính giữa sẽ có màu nâu đỏ. Phần mô ở trung tâm của khu vực bị ảnh hưởng sưng lên giống như ung thư và được bao quanh bởi một vòng hơi lõm xuống.

Sau một thời gian khi bệnh tiến triển mạnh hơn, các đốm hợp nhất với nhau và biến thành vết bệnh màu nâu sẫm, có góc cạnh không đều và kích thước khác nhau. Phần màu nâu ở chính giữa của vết bệnh khô lại và vỡ vụn, để lại những chiếc lá nhàu nát thủng rách lỗ chỗ.
Bà con cần chú ý, bệnh dễ bị nhiều bà con nhầm lẫn với căn bệnh gỉ sắt bởi các dấu hiệu của chúng khá giống nhau. Tuy nhiên, các vết đốm của bệnh gỉ sắt thường nhỏ và có hình dáng cụ thể hơn bệnh này. Ngoài bệnh gỉ sắt, căn bệnh này còn hay bị nhầm lẫn với bệnh đốm nhũn lá, bệnh đốm nhũn lá hình thành sớm một vòng nhũn nước bao quanh các đốm bệnh còn bệnh đốm lá do vi khuẩn sẽ không có đặc điểm này.
Nguyên nhân phát sinh và gây ra bệnh
Bệnh này do một loại vi khuẩn có tên khoa học là Pseudomonas savastanoi gây ra. Chúng có kích thước: 1.4 – 2.3 x 0.5 – 0.9 micron và có 1-2 roi/đầu. Đây là loài thuộc Gram âm (G-), không sinh ra bào tử, không lớp dịch nhờn. Vào thời điểm thích hợp khác nhau, mầm bệnh xâm nhập vào cây qua con đường khí khổng hoặc qua các vết tổn thương ở trên thân và bề mặt lá.
– Vi khuẩn này có thể lây lan qua hạt giống và có thể tồn tại qua mùa đông trên các tàn dư của mùa vụ trước. Mầm bệnh tồn tại từ hạt giống thường gây hại cho cây vào giai đoạn cây chỉ mới đạt 2-3 lá. Còn ở những cây trưởng thành, bệnh thường lây nhiễm và xâm nhập từ các tàn dư cây của vụ trước hoặc nhờ qua gió, nước.
– Bề mặt của tầng lá gần mặt đất rậm rạp và ẩm ướt cũng góp phần tạo điều kiện thích hợp cho sự phát triển mới của các vi khuẩn gây đốm lá.
Điều kiện phát triển
Các loại vi khuẩn này ưa thích và phát triển mạnh ở thời tiết mát mẻ, nhiệt độ khoảng 20-25 °C. Vì đặc tính sinh trưởng và phát triển thành bụi san sát nhau của cây đậu tương thế nên cũng đã góp thêm phần tạo điều kiện tốt để phát sinh và lây lan mầm bệnh nhanh chóng. Ngoài ra các điều kiện khác như gió mưa ẩm (bão) cũng là điều kiện khách quan để thúc đẩy mầm bệnh.
Mức độ ảnh hưởng
Khi bệnh phát triển ở tình trạng nặng, các phần lá này sẽ rụng hết xuống và thậm chí có thể dẫn đến tình trạng chết cây nếu bà con không có biện pháp ngăn chặn kịp thời. Ở các cây nhỏ đang trưởng thành bị bệnh nhẹ sẽ xảy ra tình trạng còi cọc ngừng phát triển và có thể chết nếu đỉnh sinh trưởng bị tổn thương quá mức. Các cây trên bị ảnh hưởng chung bởi sự phát triển của những đốm nhỏ màu vàng nâu trên lá. Ngoài ra, các vết bệnh cũng có thể trên xuất hiện trên quả làm quả bị nhăn nheo, đổi màu và biến dạng từ đó gây giảm sản lượng và cho chất lượng hạt thu hoạch kém.

Biện pháp phòng bệnh
Để có thể phòng ngừa bệnh bà con cần tham khảo và thực hiện một số biện pháp sau:
– Xử lý và tiêu huỷ các tàn dư của mùa vụ trước. Đồng thời vệ sinh sạch sẽ đồng ruộng trước và trong khi thực hiện gieo trồng và canh tác.
– Cày sâu, bừa kĩ đồng thời dùng vôi bón vào đất nhằm khử khuẩn cũng như cải tạo nâng thêm độ pH cho đất.
– Nguồn gốc giống phải được chọn lọc kỹ càng, khoẻ mạnh không mang mầm bệnh. Bà con cũng có thể sử dụng một số biện pháp xử lý giống trước khi gieo trồng
– Bà con cũng nên chọn lọc và sử dụng những giống đậu tương có khả năng kháng lại bệnh tật và chống chịu cao như: Hoà Khánh 74, Năm Căn 1, Ô Môn 1, Việt Thái 3, MTĐ9, MTĐ 13, Vân Nam,…
– Thực hiện luân canh thường xuyên cây đậu tương với các loại cây ít nhiễm bệnh khác như ngô, lúa, lạc,…

Biện pháp xử lý bệnh
Biện pháp sinh học
Biện pháp kiểm soát sinh học đối với bệnh này mà bà con có thể thực hiện là thực hiện nhổ bỏ và tiêu huỷ nếu thấy mầm bệnh xuất hiện tránh để lây lan ra diện rộng, đồng thời dùng vôi để khử khuẩn khu vực cây bị nhiễm bệnh.
Ngoài ra, trên một số tài liệu nghiên cứu cũng cho thấy, các gốc nấm đối kháng và các chủng vi khuẩn có lợi như Bacillus alcalophilus, Bacillus atrophaeus, Pseudomonas fluorescens, Bacillus subtilis,… cũng có thể gây ức chế sinh trưởng của mầm bệnh. Vì vậy bà con có thể sử dụng một số loại chế phẩm sinh học chứa nhiều vi sinh vật có lợi để điều trị. Tuy nhiên biện pháp này thường mất rất nhiều thời gian và thường không thể điều trị dứt điểm được bệnh.
Biện pháp hoá học
Vì đặc tính lây lan nhanh chóng của bệnh nên khi nhận biết được dấu hiệu phát triển của bệnh. Bà con cần thực hiện sử dụng các biện pháp điều trị sớm để nhanh chóng trị dứt điểm bệnh, đạt hiệu quả cao cũng như tiết kiệm được chi phí sử dụng các loại thuốc. Đối với căn bệnh này, bà con có thể tham khảo các loại thuốc trừ bệnh của Nghi Anh như Kibul, Nazosi, Sunfur,…
Thuốc trừ bệnh

